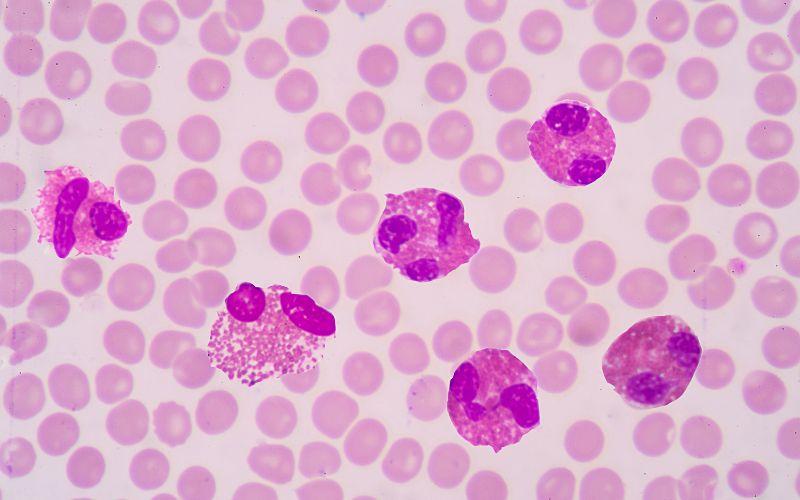

¿Qué son los eosinófilos?
Un eosinófilo es una célula de pequeño tamaño y poco abundante del tipo granulocito. Son células asociadas a respuestas hacia alergias e infecciones causadas por parásitos. Al teñir las células con eosina, estas responden coloreándose de un rojo brillante, gracias a la presencia de grandes gránulos.
Dentro de los leucocitos, los eosinófilos solo representan un pequeño porcentaje del número total, y su número aumenta en personas con condiciones médicas como fiebre, asma o presencia de parásitos.
Son células de un diámetro promedio de 12 μm y dentro de su morfología destaca la presencia de un núcleo compuesto por dos lóbulos.
Estas células pueden realizar fagocitosis, engullendo partículas foráneas o extrañas para el cuerpo. En el caso de los parásitos, estos suelen ser más grandes que el eosinófilo, por lo que engullirlo resulta complicado. Las células pueden anclarse a la superficie del parásito y empezar a producir materiales tóxicos.
De manera general, su principal modalidad de ataque es generar compuestos tóxicos en la superficie de sus objetivos, como el óxido nítrico y enzimas con capacidades citotóxicas. Estos se encuentran en el interior de sus gránulos, y se liberan durante el ataque por el parásito o durante las alergias.
Descubrimiento de los eosinófilos
La primera persona en puntualizar la existencia de los eosinófilos fue el investigador Paul Ehrlich en 1879.
Durante sus investigaciones, Ehrlich notó cómo un subtipo de leucocito sanguíneo reaccionaba con avidez al colorante ácido eosina, denominando a este nuevo componente sanguíneo como eosinófilos. Posteriormente, se lograron identificar las enzimas que existen dentro de los gránulos de la célula.
Características de los eosinófilos
- Dentro de los granulocitos (células que poseen gránulos en su interior) encontramos tres tipos: neutrófilos, basófilos y eosinófilos, que se distinguen entre sí por su morfología general y por su respuesta a las tinciones.
- Proporcionalmente, los neutrófilos son muy abundantes, constituyendo del 50 al 70% de los glóbulos blancos en circulación, mientras que los eosinófilos solo representan del 1 al 3% de estas células.
- Los eosinófilos se diferencian partiendo de células progenitoras CD34+ en la médula ósea. Su formación es inducida por una variedad de factores de transcripción y por citoquinas. De las células madres, el linaje de células mieloides permite el desarrollo de mieloblastos y luego se separan en eosinófilos.
- Los eosinófilos son células con capacidad de movimiento y de realizar fagocitosis. Estas se pueden desplazar desde la sangre hacia los espacios tisulares. Aunque su respuesta fagocítica pareciera estar opacada por los neutrófilos, los eosinófilos intervienen en la defensa contra los parásitos y en respuesta a las alergias.
- En este contexto, el eosinófilo secreta el contenido de sus gránulos eosinofílicos, que logran dañar las membranas del agente foráneo.
Morfología de los eosinófilos
Los eusinófilos reciben su nombre gracias a la presencia de gránulos de tamaño significativo refringentes en el citoplasma de la célula. Estos gránulos se tiñen de un rojo brillante cuando se aplica el colorante ácido rojo eosina, un constituyente normal de las tinciones de Romanowsky y Giemsa.
Dimensiones
Su tamaño está entre 12 y 17 µm de diámetro, comparable (o un poco más grande) al de un neutrófilo y aproximadamente 3 veces el tamaño de un eritrocito (glóbulos rojos).
Núcleo
El núcleo presenta dos lóbulos visibles. La cromatina de todos los núcleos se clasifica principalmente en dos tipos: eucromatina y heterocromatina. La primera generalmente tiene la transcripción activa y compactada levemente. La heterocromatina, por su parte, es compacta y no es activa en la transcripción.
En los eusinófilos, la heterocromatina se ubica mayormente cerca de la envoltura nuclear, mientras que la eucromatina se ubica más en el centro del núcleo.
Citoplasma
En el citoplasma de los eosinófilos encontramos los gránulos característicos de este tipo celular. Estos se clasifican en dos tipos principales: los gránulos específicos y los gránulos azurófilos. En el próximo apartado describiremos en detalle la composición y la función de cada tipo de gránulo.
Gránulos del eosinófilo
Gránulos específicos
Los gránulos específicos exhiben el cuerpo cristaloide, rodeado por una matriz menos densa. Gracias a la presencia de dichos cuerpos, los gránulos presentan la propiedad de birrefringencia (capacidad de doble refracción, desdoblando un rayo de luz en dos rayos lineales y polarizados).
Se caracterizan por la presencia de cuatro proteínas puntuales: una rica en el residuo de aminoácido arginina, denominada proteína básica mayor (MBP) o principal, bastante abundante y la responsable de la acidofilia del gránulo, la proteína catiónica del eosinófilo (ECP), la peroxidasa del eosinófilo (EPO) y la neurotoxina del eosinófilo (EDN).
Solamente la proteína básica mayor se localiza en el cuerpo cristaloide, y las demás proteínas típicas están dispersas en la matriz del gránulo. Las proteínas mencionadas exhiben propiedades tóxicas y se liberan cuando ocurren infestaciones por protozoos y helmintos parásitos.
Además, poseen fosfolipasas B y D, histaminasa, ribonucleasas, B-glucuronidasa, catepsina y colagenasa.
Proteína básica mayor (MBP)
La MPB es una proteína relativamente pequeña formada por 117 aminoácidos, con un peso molecular de 13,8 kD y un punto isoeléctrico alto, por encima de los 11. Los genes que codifican para esta proteína se encuentran en dos homólogos diferentes.
La toxicidad de la MPB frente a los helmintos ha sido comprobada. Esta proteína tiene la capacidad de aumentar la permeabilidad de la membrana a través del intercambio iónico, trayendo como consecuencia la perturbación en la agregación de los lípidos.
Proteína catiónica del eosinófilo (ECP)
La ECP es una proteína cuyo rango de tamaño va desde los 16 hasta los 21,4 kD. Este intervalo de variación puede estar influenciado por los distintos niveles de glucosilación a los que se ha encontrado la proteína. Existen dos isoformas de la ECP.
Exhibe actividad citotóxica, helmintotóxica y ribonucleasa. Además, se ha relacionado con la respuesta a la supresión de la proliferación de las células T, síntesis de inmunoglobulinas por las células B, entre otras.
Peroxidasa del eosinófilo (EPO)
Esta enzima con actividad peroxidasa está formada por dos subunidades: una cadena pesada de 50 a 57 kD y una cadena liviana de 11 a 15 kD.
La acción de esta enzima produce especies reactivas del oxígeno, metabolitos reactivos con nitrógeno y otros compuestos que promueven el estrés oxidativo, y como consecuencia, la apoptosis y la necrosis.
Neurotoxina del eosinófilo (EDN)
Esta proteína tiene actividad ribonucleasa y antiviral. Se ha encontrado que la EDN induce la maduración y la migración de las células dendríticas. También se ha relacionado con el sistema inmune adaptativo.
Aunque las cuatro enzimas descritas tienen muchos puntos en común (en términos de su función), difieren en la manera en que atacan las infestaciones por helmintos. Por ejemplo, la ECP es casi 10 veces más potente que la MBP.
Gránulos azurófilos
El segundo tipo de gránulo son lisosomas, que contienen un abanico de enzimas del tipo hidrolasas ácidas (como es común en la organela) y otras enzimas hidrolíticas que participan activamente en la lucha contra el agente patógeno y en la ruptura de los complejos antígeno-antígeno que fagocita el eosinófilo.
Funciones de los eosinófilos
- Defensa contra parásitos y respuesta a alergias. Históricamente, se ha considerado a los eosinófilos como células mieloides primitivas involucradas en la defensa contra parásitos e inflamaciones alérgicas. La liberación de arilsulfatasa e histaminasa ocurre por reacciones alérgicas. En consecuencia, la cuenta de eosinófilos suele ser elevada en pacientes que presentan esta condición.
- Homeóstasis e inmunoregulación. Actualmente, las investigaciones han revelado que esta célula también tiene un papel fundamental en la homeostasis y en la inmunorregulación. Al realizarles a ratones de laboratorio los tratamientos genéticos necesarios para truncar la producción de eosinófilos, se logró estudiar a estos roedores deficientes en eosinófilos. En estas cepas de ratones se demostró la importancia de las células de tipo granulocito en varios procesos fundamentales, como la producción de anticuerpos, la homeostasis de la glucosa y la regeneración de algunos tejidos, como el músculo y el hígado.
- Hoy en día, se ha podido establecer que la función de los eosinófilos en los seres humanos abarca aspectos más amplios que el hecho de responder a alergias y a infestaciones. Entre ellas destacan:
- Síntesis de citoquinas: los eosinófilos tienen la capacidad de sintetizar una serie de citoquinas, moléculas regulatorias de las funciones celulares que están implicadas en la comunicación. La producción de citoquinas por estas células ocurre en cantidades pequeñas.
- Papel en la reproducción: el útero es una zona rica en eosinófilos. La evidencia apunta a que estas células podrían estar implicadas en la maduración del útero y en el desarrollo de las glándulas mamarias.
Valores normales y enfermedades asociadas a los eosinófilos
Aunque puede variar entre laboratorios, se considera que una persona sana debe presentar un porcentaje de eosinófilos en la sangre en el intervalo de 0.0 a 6%. La cuenta absoluta debe estar entre 350 a 500 por mm3 de sangre. Esto quiere decir que en los individuos sanos la cuenta no es mayor a 500.
Variaciones normales en la cuenta de eosinófilos
La cuenta de eosinófilos es mayor en los niños recién nacidos y en los infantes. A medida que se avanza en edad, el número de estas células disminuye. Las mujeres embarazadas también se caracterizan por una cuenta baja de eosinófilos.
Además, la mayoría de los eosinófilos suelen residir en zonas donde existen mucosas. Son muy abundantes en el tejido conectivo ubicado en la proximidad del revestimiento del intestino, el tracto respiratorio y el tracto urogenital.
Fisiológicamente, los valores de los eosinófilos varían en la sangre periférica a lo largo del día, correspondiéndose el valor más alto de estas células a las primeras horas de la mañana, donde los picos de esteroides están en su pico más bajo.
Eosinofilia: valores altos de eosinófilos
Si la cuenta del paciente sobrepasa los 500 eosinófilos es indicativo de alguna patología y necesita un análisis médico posterior. Esta cuenta anormal es conocida en la literatura como eosinofilia. La condición suele carecer de síntomas.
Existen distintos grados de eosinofilia, dependiendo del número de eosinófilos encontrados en la muestra. Se dice que es leve si la cuenta está entre los 500 y los 1.500 mm3, moderada si la cuenta está entre 1.500 y 5.000 mm3. En caso de que la cuenta llegue a superar los 5.000 mm3 la eosinofilia es severa.
Si se llegasen a presentar síntomas, van a depender de la zona donde se encuentran los niveles alarmantes de eosinófilos, ya sea en los pulmones, corazón, estómago, entre otros órganos.
Los niños son más propensos a presentar esta condición y a adquirir múltiples infecciones por parásitos debido a su comportamiento infantil, como jugar en el suelo, tener contacto directo con mascotas sin la higiene necesaria, entre otros factores.
Síndrome hipereosinofílico
Cuando la cuenta de eosinófilos es particularmente alta y no se encuentra alguna causa inmediata (infestación por parásitos o alergias), el paciente presenta el síndrome hipereosinofílico. Esta condición es poco frecuente y suele aparecer en pacientes de sexo masculino que han superado los 50 años de edad.
El aumento de los eosinófilos sin parasitosis asociada suele causar daño en algunos órganos, generalmente el corazón, el sistema nervioso y los pulmones. El daño severo se presenta si la condición hipereosinofílica es persistente.
Existen dos tipos de la enfermedad: la mieloprofilerativa, asociada a la pérdida de un segmento de ADN en el cromosoma cuatro, y la variante linfoproliferativa, asociada con un fenotipo aberrante de los linfocitos T.
Para restablecer los valores normales de estas células, el médico puede recetar ciertos medicamentos (imatinib es uno de los más frecuentes).
Valores bajos de eosinófilos
La cuenta baja de eosinófilos está relacionada con el síndrome de Cushing, una condición médica asociada a valores altos de cortisol, y se caracteriza por un aumento de peso en el paciente gracias a la distribución desproporcional de la grasa en el cuerpo.
Otras causas que pueden disminuir el número de los eosinófilos son las infecciones en la sangre y la toma de esteroides. Cuando el médico aborda de manera óptima estas condiciones, el número de eosinófilos se restablece.
Una cuenta baja de eosinófilos no suele ser muy alarmante, ya que otras células del sistema inmune pueden compensar su trabajo.
Referencias
- Blanchard, C., & Rothenberg, M. E. Biology of the eosinophil. Advances in immunology.
- Kim, Y. J., & Nutman, T. B. Eosinophilia. In Immigrant Medicine. WB Saunders.
- Klion A. Recent advances in understanding eosinophil biology.
- Lanzkowsky, P. Manual of pediatric hematology and oncology. Elsevier.
- Ross, M. H., & Pawlina, W. Histology. Lippincott Williams & Wilkins.